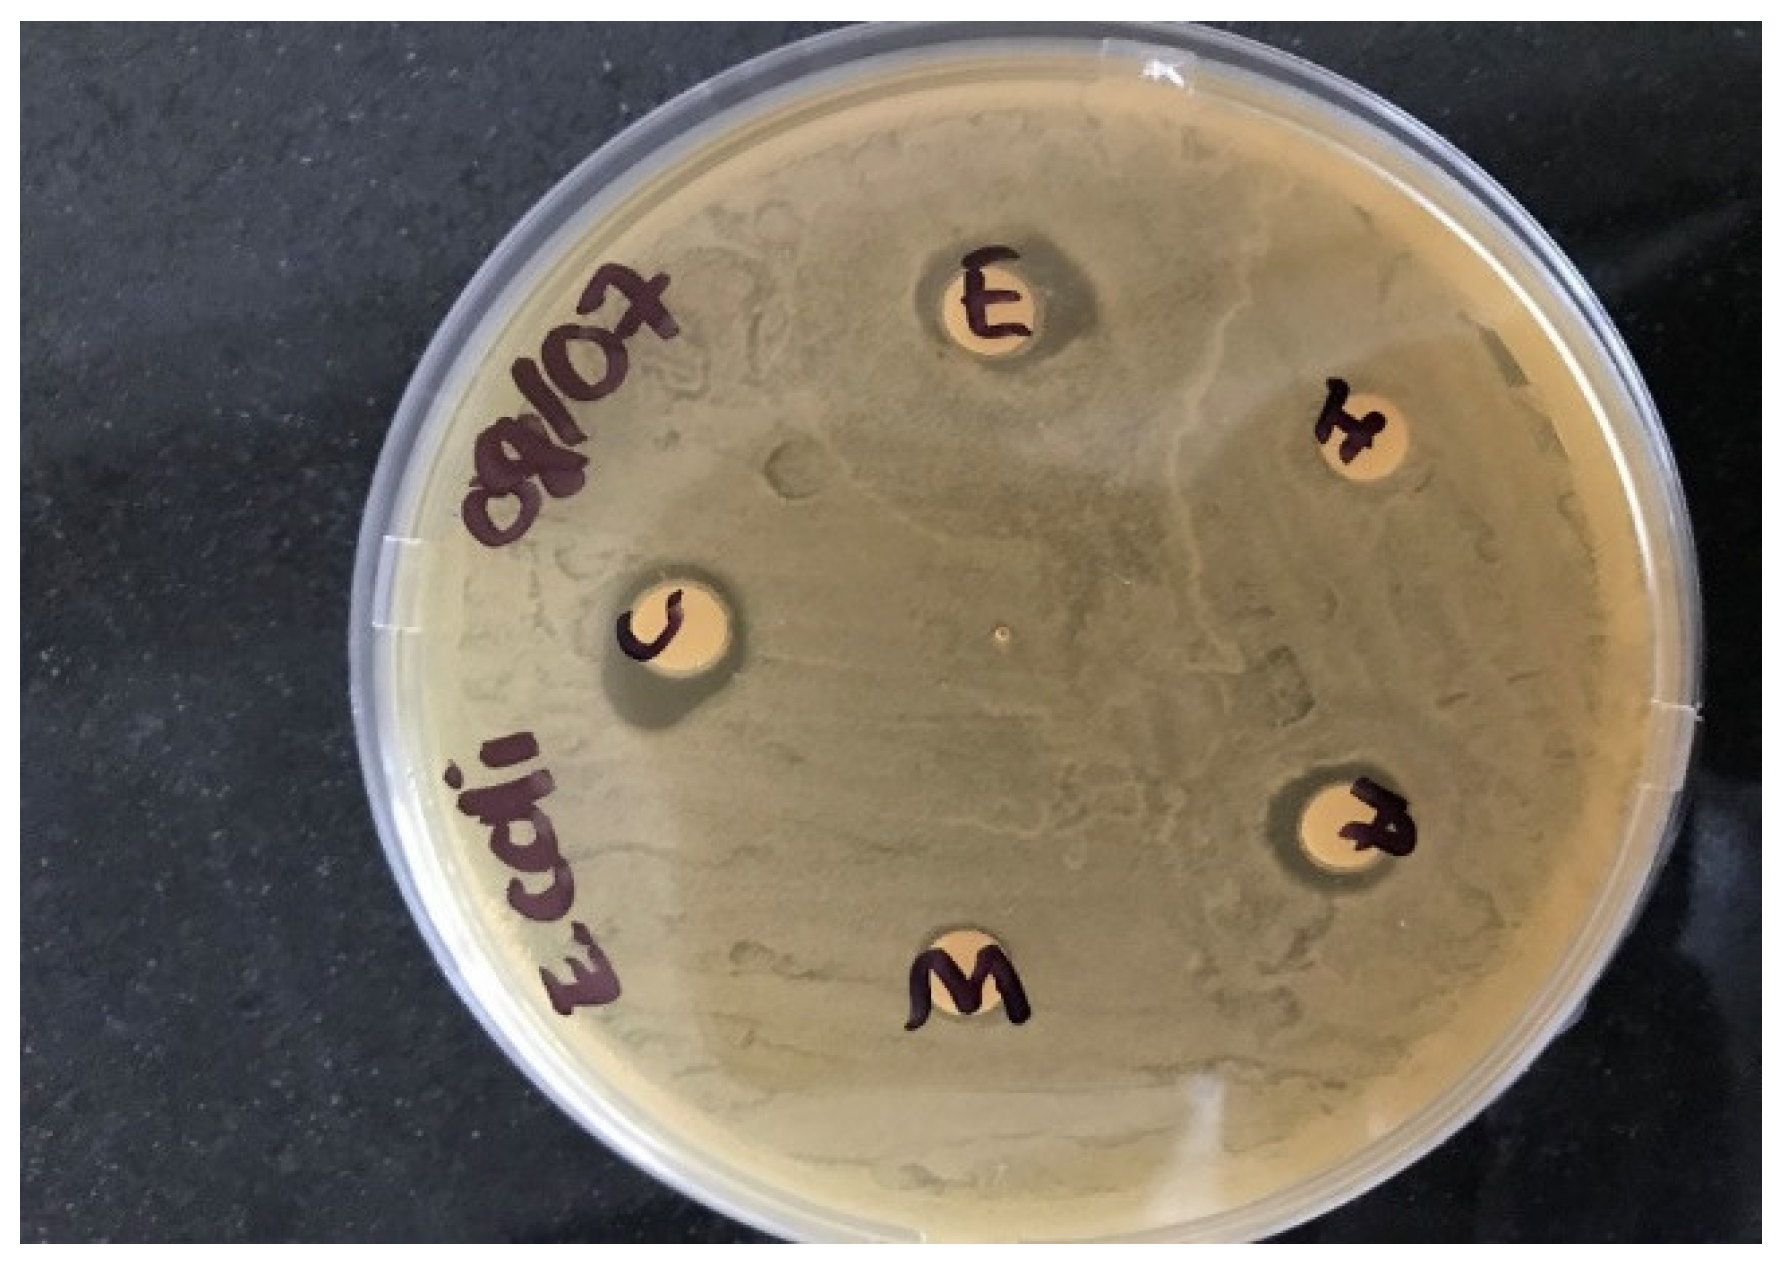
Ijerph 19 05462 g002 550

Antimicrobial Activity of Sunflower (Helianthus annuus) Seed for Household Domestic Water Treatment in Buhera District, Zimbabwe
Abstract
:1. Introduction
2. Materials and Methods
2.1. Description of the Study Area
2.2. Selection of Water Sampling Sites
2.3. Water Sampling Methods
Statistical Analysis
2.4. Sunflower Seed Extraction
2.5. Determination of Sunflower Seed Antimicrobial Activities
2.5.1. Test Isolate Preparation
2.5.2. Disc Preparation
2.5.3. Application of the Discs
2.5.4. Experimental Implementation
3. Results and Discussion
3.1. Water Quality in Buhera District
3.1.1. Bacteriological Contamination in Borehole Water
3.1.2. Bacteriological Contamination in River Water
3.2. Activities of Sunflower Seed Extracts against Bacteriological Contaminants
3.2.1. E. coli
3.2.2. Total Coliforms
3.2.3. Faecal Coliforms
3.3. Effectiveness of Sunflower Seed Extracts against E. coli, Total Coliforms, and Faecal Coliforms
3.4. Results for Water Treatment Using Sunflower Seed Extracts
4. Conclusions and Recommendations
Author Contributions
Funding
Institutional Review Board Statement
Informed Consent Statement
Data Availability Statement
Acknowledgments
Conflicts of Interest
References
- Afroz, R.; Banna, H.; Masud, M.M.; Akhtar, R.; Yahaya, S.R. Household’s perception of water pollution and its economic impact on human health in Malaysia. Desalin Water Treat. 2015, 57, 115–123. [Google Scholar] [CrossRef]
- Stevens, A.P.; Grasso, R.J.; Delaney, J.E. Measurements of faecal coliform in estuarine water. In Proceedings of the 8th National Shellfish Sanitation Workshop; U.S Health, Education and Welfare: Washington, DC, USA, 2003. [Google Scholar]
- Zimbabwe National Statistical Agency. Inventory of Facilities and Social Amenities (IFSA) in Rural District Councils; Zimbabwe National Statistical Agency: Harare, Zimbabwe, 2014. [Google Scholar]
- Edition, F. Guidelines for Drinking-Water Quality; WHO Chronicle: Geneva, Switzerland, 2011; Volume 38, pp. 104–108. [Google Scholar]
- Khan, S.; Shahnaz, M.; Jehan, N.; Rehman, S.; Shah, M.T.; Din, I. Drinking water quality and human health risk in Charsadda district, Pakistan. J. Clean. Prod. 2013, 60, 93–101. [Google Scholar] [CrossRef]
- Delpla, I.; Rodriguez, M.J. Variability of disinfection by-products at a full-scale treatment plant following rainfall events. Chemosphere 2017, 166, 453–462. [Google Scholar] [CrossRef] [PubMed]
- Momba, M.; Obi, C.; Thompson, P. Survey of disinfection efficiency of small drinking water treatment plants: Challenges facing small water treatment plants in South Africa. Water SA 2009, 35. [Google Scholar] [CrossRef] [Green Version]
- Kumar, V. Phytoremediation of distillery effluent: Current progress, challenges, and future. In Bioremediation for Environmental Sustainability: Toxicity, Mechanisms of Contaminants Degradation, Detoxification and Challenges; Saxena, G., Kumar, V., Shah, M.P., Eds.; Elsevier: Amsterdam, The Netherlands, 2020; pp. 349–374. [Google Scholar] [CrossRef]
- Sharma, P.; Pandey, A.K.; Udayan, A.; Kumar, S. Role of microbial community and metal-binding proteins in phytoremediation of heavy metals from industrial wastewater. Bioresour. Technol. 2021, 326, 124750. [Google Scholar] [CrossRef]
- Fowler, M.W. Plants, medicines and man. J. Sci. Food Agr. 2006, 86, 1797–1804. [Google Scholar] [CrossRef]
- Vassilev, S.V.; Baxter, D.; Andersen, L.K.; Vassileva, C.G. An overview of the composition and application of biomass ash. Part 2. Potential utilisation, technological and ecological advantages and challenges. Fuel 2013, 105, 19–39. [Google Scholar] [CrossRef]
- Ashbolt, N. The microbiological quality of bottled water. J. Appl. Bacter. 2001, 74, 345–352. [Google Scholar]
- Ouf, S.A.; Yehia, R.S.; Ouf, A.S.; Abdul-Rahim, R.F. Bacterial contamination and health risks of drinking water from the municipal non-government managed water treatment plants. Environ. Monit. Assess. 2018, 190, 685. [Google Scholar] [CrossRef]
- Aziz, F.M.; Darweesh, M.J.; Rahi, F.A.; Saeed, R.T. In vivo and in vitro studies of a polar extract of Helianthus annuus (Sunflower) seeds in treatment of Napkin Dermatitis. Int. J. Pharm. Sci. Rev. Res. 2014, 24, 1–3. [Google Scholar]
- Matasyoh, L.G.; Matasyoh, J.C.; Wachira, F.N.; Kinyua, M.G.; Muigai AW, T.; Mukiama, T.K. Chemical composition and antimicrobial activity of the essential oil of Ocimum gratissimum L. growing in Eastern Kenya. Afr. J. Biotechnol. 2007, 6, 760–765. [Google Scholar]
- Saini, S.; Sharma, S. Antidiabetic effect of Helianthus annuus seeds ethanolic extract in streptozotocinnicotinamide induced type 2 diabetes mellitus. Int. J. Pharm. Pharm. Sci. 2013, 5, 382–387. [Google Scholar]
- Bashir, T.; Zahara, K.; Haider, S.; Tabassum, S. Chemistry, pharmacology and ethnomedicinal uses of H. annuus (sunflower): A review. Pure Appl. Biol. 2015, 4, 226–230. [Google Scholar] [CrossRef]
- Ahmad, S.; AbdEl-Salam, N.M.; Ullah, R. In Vitro Antimicrobial bioassays, DPPH radical scavenging activity, and FTIR spectroscopy analysis of Heliotropium bacciferum. Biomed Res Int. 2016, 2016, 3818945. [Google Scholar] [CrossRef] [PubMed] [Green Version]
- Government of Zimbabwe. Environmental Management Policies and Strategies for Environmental Impact Assessment; Government of Zimbabwe: Harare, Zimbabwe, 2013. [Google Scholar]
- Central Statistical Office (CSO). The 2012 Population Census for Zimbabwe, Government of Zimbabwe; CSO: Harare, Zimbabwe, 2014. [Google Scholar]
- American Public Health Association (APHA). Standard Methods for the Examination of Water and Wastewater, 20th ed.; APHA: Washington, DC, USA, 1998. [Google Scholar]
- Feng, P.; Weagant, S.D.; Grant, M.A.; Burkhardt, B.A.M. Standard enumeration of Escherichia coli and the coliform bacteria. Int. J. Environ. Res. Public Health 2012, 10, 80–89. [Google Scholar]
- Rompre’, A.; Servais, P.; Baudart, J.; de-Roubin, M.; Laurent, P. Detection and enumeration of coliforms in drinking water: Current methods and emerging approaches. J. Microbiol. Meth. 2002, 49, 31–54. [Google Scholar] [CrossRef]
- Paruch, A.M.; Mæhlum, T. Specific features of Escherichia coli that distinguish it from coliform and thermotolerant coliform bacteria and define it as the most accurate indicator of faecal contamination in the environment. Ecol. Indic. 2012, 23, 140–142. [Google Scholar] [CrossRef]
- Salle, A.J. Laboratory Manual on Fundamental Principles of Bacteriology, 4th ed.; McGraw-Hill Book Company, Inc.: New York, NY, USA, 1954. [Google Scholar]
- Anbazhagan, D.; Mui, W.S.; Mansor, M.; Yan, G.O.S.; Yusof, M.Y.; Sekaran, S.D. Development of conventional and real-time multiplex PCR assays for the detection of nosocomial pathogens. Braz. J. Microbiol. 2011, 42, 448–458. [Google Scholar] [CrossRef]
- Sambrook, J.; Fritsch, E.R.; Maniatis, T. Molecular Cloning: A Laboratory Manual, 2nd ed.; Cold Spring Harbor Laboratory Press: Cold Spring Harbor, NY, USA, 1989. [Google Scholar]
- Awotedu, O.L.; Okeke, U.E.; Ogunbamowo, P.O.; Ariwoola, O.S.; Omolola, T.O. Extraction of Phytochemical Compounds of Leea guineensis (G. Don) Leaves Using Non-polar and Polar Solvents. Eur. J. Med. Plants 2020, 31, 24–31. [Google Scholar] [CrossRef] [Green Version]
- Craun, J.; Calderon, C. Coliforms and E. coli; Royal Society of Chemistry: Leeds, UK, 2001. [Google Scholar]
- Younes, M.; Bartram, J. Waterborne health risks and the WHO perspective. Int. J. Hyg. Environ. Health 2001, 204, 255–263. [Google Scholar] [CrossRef]
- WHO. Guidelines for Drinking Water Quality; World Health Organization: Geneva, Switzerland, 2017. [Google Scholar]
- Environmental Management Agency. Water Quality in Zimbabwe: Environmental Management Authority; Environmental Management: Harare, Zimbabwe, 2008. [Google Scholar]
- Nealson, K.H. Harnessing microbial appetites for remediation. Nat. Biotechnol. 2003, 21, 243–244. [Google Scholar] [CrossRef] [PubMed]
- Obi, C.L.; Potgieter, N.; Bessong, P.O.; Matsaung, G. Assessment of the microbial quality of river water sources in rural Venda communities in South Africa. Water SA 2002, 28, 287–292. [Google Scholar] [CrossRef] [Green Version]
- Vijay, R.; Sardar, V.K.; Dhage, S.S.; Kelkar, P.S.; Gupta, A. Hydrodynamic assessment of sewage impact on water quality of Malad Creek, Mumbai, India. Environ. Monit. Assess. 2009, 165, 559–571. [Google Scholar] [CrossRef] [PubMed]
- Kamal, J. Quantification of alkaloids, phenols and flavonoids in sunflower (Helianthus annuus). Afr. J. Biotechn. 2011, 10, 31–49. [Google Scholar]
- Rakhshaee, R.; Giahi, M.; Pourahmad, A. Studying effect of cell wall’s carboxyl-carboxylate ratio change of Lemna minor to remove heavy metals from aqueous solution. J. Hazard. Mater. 2018, 163, 165–173. [Google Scholar] [CrossRef]
- Ukiya, M.; Akihisa, T.; Yasukawa, K.; Koike, K.; Takahashi, A.; Suzuki, T.; Kimura, Y. Triterpene Glycosides from the Flower Petals of Sunflower (Helianthus annuus) and Their Anti-inflammatory Activity. J. Nat. Prod. 2007, 70, 813–816. [Google Scholar] [CrossRef]
- Kay, D.; Fricker, C. Coliforms and E. Coli Problem or Solution; Royal Society of Chemistry: Leeds, UK, 2007; p. 180. [Google Scholar]
- Bere, S. Waste management issues in Zimbabwe. J. Sustain. Dev. Afr. 2011, 21, 1123–1127. [Google Scholar]
- Treacy, J. Drinking water treatment and challenges in developing countries. In The Relevance of Hygiene to Health in Developing Countries; Potgieter, N., Ed.; Intechopen: London, UK, 2019; pp. 55–77. [Google Scholar] [CrossRef] [Green Version]
- Ruth, A.J. Response of Fresh-Water Protozoan Artificial Communities to Metals. Protozoa 2010, 20, 127. [Google Scholar]
- Subashini, R.; Rakshitha, S.U. Phytochemical screening, antimicrobial activity and in vitro antioxidant investigation of methanolic extract of seeds from Helianthus annuus L. Chem Sci Rev Lett. 2012, 1, 30–34. [Google Scholar]
- Aboki, M.A.; Mohammed, M.; Musa, M.; Zuru, S.H.; Aliyu, B.S.; Gero, H.M.; Inuwa, M. Physicochemical and Antimicrobial Properties of Sunflower (Helianthus annuus L.) Seed Oil. Int. J. Sci. Technol. 2012, 2, 2224–3577. [Google Scholar]
- Hernández-Villegas, M.; Borges-Argáez, R.; Rodriguez-Vivas, R.; Torres-Acosta, J.; Méndez-Gonzalez, M.; Cáceres-Farfan, M. Ovicidal and larvicidal activity of the crude extracts from Phytolacca icosandra against Haemonchus contortus. Veter Parasitol. 2011, 179, 100–106. [Google Scholar] [CrossRef] [PubMed]
- D’Addabbo, T.; Carbonara, T.; Leonetti, P.; Radicci, V.; Tava, A.; Avato, P. Control of plant parasitic nematodes with active saponins and biomass from Medicago sativa. Phytochem. Rev. 2010, 10, 503–519. [Google Scholar] [CrossRef]
- Macler, C.A.; Merkel, B.J. Current knowledge on groundwater microbial pathogens and their control. Hydrogeol. J. 2000, 8, 29–40. [Google Scholar] [CrossRef]

| Primer | Primer Sequence (5′ to 3′) | Targeted Gene | Amplicon Size (bp) | Reference |
|---|---|---|---|---|
| uidA | (F) CTGGTATCAGCGCGAAGTCT (R) AGCGGGTAGATATCACACTC | uidA | 600 | [26] |
| Number of Replication | Solvents for Plant Extract | ||||
|---|---|---|---|---|---|
| Chloroform | Ethanol | Hexane | Water | Acetone | |
| 1 | 5 ± 0.5 mm | 3 ± 0.2 mm | 0 mm | 4 ± 0.5 mm | 3 ± 0.1 mm |
| 2 | 5 ± 0.1 mm | 4 ± 0.0 mm | 0 mm | 0 ± 0.0 mm | 4 ± 0.2 mm |
| 3 | 5 ± 0.3 mm | 3 ± 0.4 mm | 0 mm | 5 ± 0.2 mm | 4 ± 0.5 mm |
| Parameter (cfu/100 mL) | Section of the River | Season | Drinking Water Standards | ||||||
|---|---|---|---|---|---|---|---|---|---|
| Summer | Winter | Autumn | SAZ | WHO | |||||
| Mean ± SD | p-Value | Mean ± SD | p-Value | Mean ± SD | p-Value | ||||
| Total coliforms | Upper | 2.4 ± 0.1 | 0.02 | 0.9 ± 0.2 | 0.95 | 1.9 ± 0.3 | 0.000 | 0 | 0 |
| Middle | 4.3 ± 0.4 | 0.027 | 1.3 ± 0.2 | 0.67 | 2.0 ± 0.1 | 0.040 | |||
| Lower | 1.8 ± 0.2 | 0.000 | 2 ± 0.1 | 0.45 | 1.1 ± 0.2 | 0.013 | |||
| Faecal coliforms | Upper | 2 ± 0.4 | 0.043 | 0.6 ± 0.3 | 0.376 | 1.3 ± 0.1 | 0.023 | 0 | 0 |
| Middle | 4.1 ± 0.2 | 0.087 | 1.2 ± 0.3 | 1 | 2.7 ± 0.5 | 0.000 | |||
| Lower | 3.5 ± 0.2 | 0.09 | 0.9 ± 0.2 | 0.71 | 1.9 ± 0.4 | 0.068 | |||
| E. coli | Upper | 1.7 ± 0.2 | 0.01 | 0.2 ± 0.1 | 0.665 | 0.6 ± 0.3 | 0.025 | <1 | 0 |
| Middle | 3.4 ± 0.1 | 0.000 | 1.1 ± 0.4 | 0.999 | 1.7 ± 0.4 | 0.074 | |||
| Lower | 3.9 ± 0.1 | 0.004 | 0.9 ± 0.3 | 0.833 | 1.1 ± 0.2 | 0.000 | |||
| Bacterial Species | Dosage (g) | |||
|---|---|---|---|---|
| 0.5 g | 1 g | 2 g | 3 g | |
| E. coli | 7 ± 0.2 mm | 9 ± 0.2 mm | 11 ± 0.3 mm | 13 ± 0.3 mm |
| Total coliforms | 6 ± 0.5 mm | 7 ± 0.7 mm | 9 ± 0.6 mm | 11 ± 0.4 mm |
| Faecal coliforms | 7 ± 0.1 mm | 8 ± 0.2 mm | 10 ± 0.3 mm | 11 ± 0.3 mm |
| Borehole Number | Parameters (cfu/100 mL) | |||||
|---|---|---|---|---|---|---|
| First Treatment (2 g) | Second Treatment (4 g) | |||||
| Total Coliform | Faecal Coliform | E. coli | Total Coliform | Faecal Coliform | E. coli | |
| 06 | 0 (1.2 ± 0.4) | 0 (0) | 0 (0.5) | 0 | 0 | 0 |
| Section of River | ||||||
| Upper | 0 (2.4 ± 0.1) | 0 (2 ± 0.4) | 0 (1.7 ± 0.2) | 0 | 0 | 0 |
| Middle | 0.7 ± 0.2 (4.3 ± 0.4) | 1.0 ± 0.1 (4.1 ± 0.2) | 0.3 ± 0.2 (3.4 ± 0.1) | 0 | 0 | 0 |
| Lower | 0 (1.8 ± 0.2) | 0.4 ± 0.3 (3.5 ± 0.2) | 0.8 ± 0.1 (3.9 ± 0.1) | 0 | 0 | 0 |
Publisher’s Note: MDPI stays neutral with regard to jurisdictional claims in published maps and institutional affiliations. |
© 2022 by the authors. Licensee MDPI, Basel, Switzerland. This article is an open access article distributed under the terms and conditions of the Creative Commons Attribution (CC BY) license (https://creativecommons.org/licenses/by/4.0/).
Share and Cite
Mahamba, C.; Palamuleni, L.G. Antimicrobial Activity of Sunflower (Helianthus annuus) Seed for Household Domestic Water Treatment in Buhera District, Zimbabwe. Int. J. Environ. Res. Public Health 2022, 19, 5462. https://doi.org/10.3390/ijerph19095462
Mahamba C, Palamuleni LG. Antimicrobial Activity of Sunflower (Helianthus annuus) Seed for Household Domestic Water Treatment in Buhera District, Zimbabwe. International Journal of Environmental Research and Public Health. 2022; 19(9):5462. https://doi.org/10.3390/ijerph19095462
Chicago/Turabian StyleMahamba, Caston, and Lobina G. Palamuleni. 2022. "Antimicrobial Activity of Sunflower (Helianthus annuus) Seed for Household Domestic Water Treatment in Buhera District, Zimbabwe" International Journal of Environmental Research and Public Health 19, no. 9: 5462. https://doi.org/10.3390/ijerph19095462
APA StyleMahamba, C., & Palamuleni, L. G. (2022). Antimicrobial Activity of Sunflower (Helianthus annuus) Seed for Household Domestic Water Treatment in Buhera District, Zimbabwe. International Journal of Environmental Research and Public Health, 19(9), 5462. https://doi.org/10.3390/ijerph19095462

